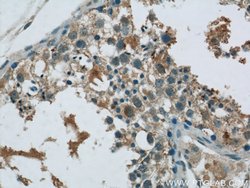

Promotional price valid on web orders only. Your contract pricing may differ. Interested in signing up for a dedicated account number?
Learn More
Learn More
MEX3C Rabbit anti-Human, Mouse, Polyclonal, Proteintech


Rabbit Polyclonal Antibody
Supplier: Proteintech Group Inc 228821AP150UL

Description
Rkhd2, also known as MEX3C is a member of a novel family of four homologous human MEX3 proteins each containing two heterogeneous nuclear ribonucleoprotein K homology (KH) domains and one carboxy-terminal RING finger module. MEX3 proteins, including Rkhd2, are phosphoproteins that bind RNA through their KH domains and shuttle between the nucleus and the cytoplasm via the CRM1 export pathway. These proteins are a novel family of evolutionarily conserved RNA-binding proteins, differentially recruited to P bodies and potentially involved in post-transcriptional regulatory mechanisms. It has been suggested that genetic variations in Rkhd2 may be associated with susceptibility to essential hypertension type 8. Rkhd3 and Rkhd4, but not Rkhd2, co-localize with both the hDcp1a decapping factor and Argonaute (Ago) proteins in processing bodies (P bodies), recently characterized as centers of mRNA turnover.Specifications
| MEX3C | |
| Polyclonal | |
| Unconjugated | |
| MEX3C | |
| BM 013, mex 3 homolog C (C. elegans), MEX 3C, MEX3C, RING finger protein 194, RKHD2, RNA binding protein MEX3C, RNF194 | |
| Rabbit | |
| Antigen Affinity Chromatography | |
| RUO | |
| 240396, 51320 | |
| -20°C | |
| Liquid |
| Immunocytochemistry, Immunofluorescence, Immunohistochemistry (Paraffin), Western Blot | |
| 0.15 mg/mL | |
| PBS with 50% glycerol and 0.02% sodium azide; pH 7.3 | |
| Q05A36, Q5U5Q3 | |
| MEX3C | |
| MEX3C Fusion Protein Ag18931 | |
| 150 μL | |
| Primary | |
| Human, Mouse | |
| Antibody | |
| IgG |
Product Content Correction
The Fisher Scientific Encompass Program offers items which are not part of our distribution portfolio. These products typically do not have pictures or detailed descriptions. However, we are committed to improving your shopping experience. Please use the form below to provide feedback related to the content on this product.
Product Title
Spot an opportunity for improvement?Share a Content Correction